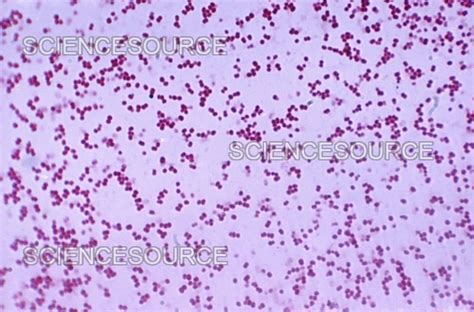
Mikroskopický snímok baktérie Moraxella catarrhalis

Nástup dieťaťa do kolektívu, či už do materskej školy alebo prvého ročníka základnej školy, často sprevádza zvýšená chorobnosť. Malý organizmus sa stretáva s novými vírusmi a baktériami, na ktoré si postupne buduje imunitu. Tento proces, hoci prirodzený, môže byť pre rodičov frustrujúci, najmä ak dieťa trpí opakovanými ochoreniami dýchacích ciest či inými infekciami. Časté sople, kašeľ, či dokonca zápaly priedušiek alebo uší sa stávajú bežnou súčasťou života mnohých rodín.
Prečo je dieťa v škôlke stále choré?
Imunitný systém dieťaťa sa vyvíja postupne. Po narodení je jeho imunita naivná a nezrelá, bez dostatočnej "pamäte" na boj s patogénmi. Pri nástupe do škôlky sa mení nielen denný režim dieťaťa, ale aj jeho prostredie. Denne prichádza do kontaktu s množstvom nových podnetov, kamarátov, ale aj s baktériami a vírusmi, ktoré sa v kolektíve šíria oveľa rýchlejšie. Veľký kolektív a vonkajšie ochladenie navyše imunitu dieťaťa poriadne potrápia. Mnohé deti pohromade znamenajú vyššiu šancu na šírenie baktérií a vírusov. Je dôležité uvedomiť si, že dieťa si práve takýmto spôsobom buduje svoju imunitu a musí z týchto ochorení vyrásť.

Najčastejšie detské choroby v škôlke
V prostredí materských škôl sa najčastejšie vyskytujú rôzne typy infekcií. Medzi tie najbežnejšie patria:
Infekcie horných dýchacích ciest
Asi najčastejším detským ochorením u škôlkarov sú zápaly horných dýchacích ciest, ako napríklad zápal podnebných mandlí alebo zápal prínosových dutín. Šíria sa prevažne kvapôčkovou infekciou, keď nakazené dieťa kašľaním, kýchaním alebo blízkym kontaktom s inými deťmi prenáša ochorenie. Jednou z možných komplikácií infekcie horných dýchacích ciest môže byť aj zápal stredného ucha, ktorý vzniká napríklad vtedy, keď si dieťa počas ochorenia nedostatočne fúka nos.
Zápal priedušiek
Ďalším veľmi častým ochorením u detí navštevujúcich škôlku je zápal priedušiek. Ide o ochorenie dolných dýchacích ciest, ktoré je spravidla vírusového pôvodu - najčastejšie ide o vírusy chrípky, parachrípky, rinovírusy či adenovírusy. Okrem toho ho môžu spôsobovať aj baktérie, ako napríklad Streptococcus pneumoniae. U detí sa často objavuje namáhavé dýchanie a pískanie pri výdychu. Nesprávne alebo nedostatočne liečený zápal priedušiek môže viesť až k vzniku zápalu pľúc. V prípade podozrenia na zápal priedušiek je nevyhnutné obrátiť sa na lekára.
Črevné virózy
Tretie ochorenie, ktoré je u detí veľmi časté, je hnačka. Črevné virózy sú vo väčšine prípadov vírusového charakteru, avšak deťom sa nevyhýba ani salmonela. Hnačky nie sú vo veľkých detských kolektívoch ničím nezvyčajným a môžu sa u vášho drobca objaviť aj niekoľkokrát ročne. Pri hnačke je veľmi dôležité, aby dieťa prijímalo dostatok tekutín a vyhlo sa tak dehydratácii. Keďže ide o akútny problém, je potrebné ho riešiť čo najskôr.
Šiesta choroba (Roseola infantum)
Šiesta choroba je vírusové ochorenie spôsobené ľudským herpetickým vírusom, ktoré sa veľmi ľahko šíri kvapôčkovou infekciou. Ide o pomerne časté detské ochorenie u detí do 3 rokov života. Prejavuje sa horúčkou, vyrážkou a v niektorých prípadoch aj zvýšenou sekréciou z nosa. Inkubačná doba ochorenia je 5 až 12 dní a samotné ochorenie trvá zhruba týždeň. Ochorenie nastupuje sprudka - horúčkou, pričom teplota počas ochorenia kolíše. Najcharakteristickejší je výsyp, ktorý sa objaví po odznení horúčky a pretrváva niekoľko hodín až dva dni. Objavuje sa spravidla na hrudníku, trupe a pokračuje na končatiny dieťaťa. Výsyp má ružovú až červenú farbu, je plošný, bez pľuzgierov, nebolí a ani nesvrbí. Dieťa trpiace šiestou chorobou je často nervózne, podráždené a unavené.

Choroba ruky-nohy-ústa (Siedma choroba)
Ochorenie ruky-nohy-ústa, inak nazývané aj siedma choroba alebo ochorenie špinavých rúk, je nepríjemné a veľmi infekčné ochorenie. Najčastejšie sa objavuje u batoliat, no nevyhýba sa ani deťom v predškolskom veku. Prejavuje sa výsypom v ústnej dutine, okolí úst a tiež na dlaniach a chodidlách.
Baktéria Moraxella catarrhalis a jej vplyv na časté ochorenia
Niektoré deti môžu mať v nosohltane prítomné baktérie ako Moraxella catarrhalis či Haemophilus parainfluenzae. Tieto baktérie sa často vyskytujú v horných dýchacích cestách a môžu prispievať k opakovaným infekciám, najmä ak je imunitný systém dieťaťa oslabený. V niektorých prípadoch, ak dieťa nemá žiadne klinické príznaky, hovoríme o tzv. asymptomatickom nosičstve. To znamená, že baktéria je prítomná, ale nespôsobuje žiadne ťažkosti. Avšak, aj bezpríznakové nosičstvo môže byť zdrojom infekcie pre iných, najmä ak dôjde k oslabeniu imunity u samotného nosiča.
Ako podporovať imunitu u detí?
Podpora imunity dieťaťa je kľúčová pre jeho celkové zdravie a odolnosť voči infekciám. Existuje niekoľko osvedčených spôsobov, ako posilniť imunitný systém:
Zdravá strava
Najväčšia časť imunitného systému sa nachádza v čreve. Preto je dôležité podávať dieťaťu stravu, ktorá bude zdravá, nutrične vyvážená a bude podporovať zdravie črevnej mikroflóry. Vitamíny, minerály, vláknina, bielkoviny a zdravé sacharidy by na tanieri vášho drobca určite nemali chýbať. V prípade, že dieťa odmieta jesť zeleninu a ovocie, je možné siahnuť po probiotikách, ktoré pomáhajú obnoviť rovnováhu črevnej mikroflóry.
Pohyb na čerstvom vzduchu
Dieťa by malo vonku na čerstvom vzduchu tráviť priemerne 2 hodiny denne. Pohyb je celkovo dobrý pre deti a samozrejme aj pre dospelých. Prechádzkou na čerstvom vzduchu, prípadne nejakým tým ľahkým športom nič nepokazíte - nezabudnite však dieťa primerane obliecť.
Dostatočný spánok
Spánok slúži nielen na to, aby si dieťa oddýchlo od hrania a denných aktivít. Je tiež dôležitý pre zdravie, fungovanie tela a obranyschopnosť. Nedostatok spánku môže oslabiť imunitný systém a urobiť dieťa náchylnejším na ochorenia.
Hygiena s mierou
Mnohí rodičia sa snažia všetko v okolí dieťaťa udržať až sterilne čisté. Izba, oblečenie, detské hračky - všetko sa priam blyští. Na jednej strane je to pochopiteľné, pretože na predmetoch, s ktorými sa dieťa dostáva do styku, sa môžu nachádzať baktérie. Avšak, aj pri hygiene platí, že všetko treba s mierou. Deťom, ktoré sa pohybujú v „sterilnom“ prostredí sa nevyvíja získaná imunita tak, ako iným deťom. Postupné vystavovanie sa bežným mikroorganizmom pomáha imunitnému systému učiť sa a posilňovať sa.
Probiotiká a vitamíny
Pre deti mladšie ako 1 rok je možnosťou posilniť imunitu užívaním probiotík, ako sú napríklad Probio-fix inum baby, ktoré obsahujú prospešné baktérie Lactobacillus rhamnosus a Bifidobacterium animalis. Tieto kmene pomáhajú inhibovať rast patogénov v črevách a posilňujú imunitný systém. Vhodné je podávať aj vitamín C, ktorý bojuje voči baktériám a vírusom a skracuje dobu liečby počas nachladnutia.
Čo môžem urobiť pre posilnenie imunitného systému môjho dieťaťa?
Kedy navštíviť lekára?
Pokiaľ máte doma choré dieťa, určite nepatrí do školy ani škôlky. V kolektíve sa veľmi rýchlo šíria infekcie a bacily. To môže mať za následok nielen to, že vaše dieťa nakazí iné deti, ale môže sa tiež zhoršiť jeho zdravotný stav. Návrat do školy by mal prebiehať po kontrole u lekára, ktorý vyhodnotí, že dieťa už nie je infekčné, respektíve, že je dostatočne zdravé na návrat do kolektívu. V prípade pretrvávajúcej chorobnosti, častých zápalov alebo podozrenia na vážnejšiu infekciu je vždy dôležité poradiť sa s pediatrom.
